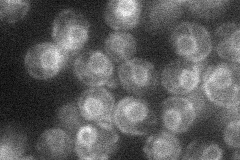
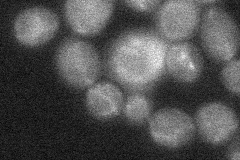

View description
Putative ferric reductase with similarity to Fre2p; expression induced by low copper levels
Localization:
Intensity:
Fold change:
Significance:
-
C’ GFP library in SD

below threshold16.71 -
N' NOP1pr-GFP in SD

ER34.6988 -
N' TEF2pr-mCherry in SD
ER19.3421 -
N' NATIVEpr-GFP in SD

below threshold19.2911 -
N' TEF2pr-VC and Cyto-VN in SD
below threshold23.032 -
C’ GFP library in SD+DTT

cytosol17.881.07No -
C’ GFP library in SD+H2O2

cytosol18.31.09No -
C’ GFP library in Starvation Media

cytosol15.250.91No -
C’ GFP library on the background of Pup2-DaMP

below threshold -
C’ GFP library on the background of CCT mutant

below threshold18.06491.08074No
